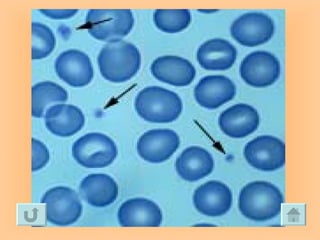

Embed presentation
Download as PPS, PPTX










































The document lists and describes the main systems and organs that make up the human body. It discusses the digestive system including the mouth, esophagus, stomach, liver, teeth, tongue, large intestine, small intestine and anus. It also lists the muscular, skeletal, respiratory and circulatory systems and some of their key components like biceps, triceps, ribs, lungs, heart, arteries and veins.